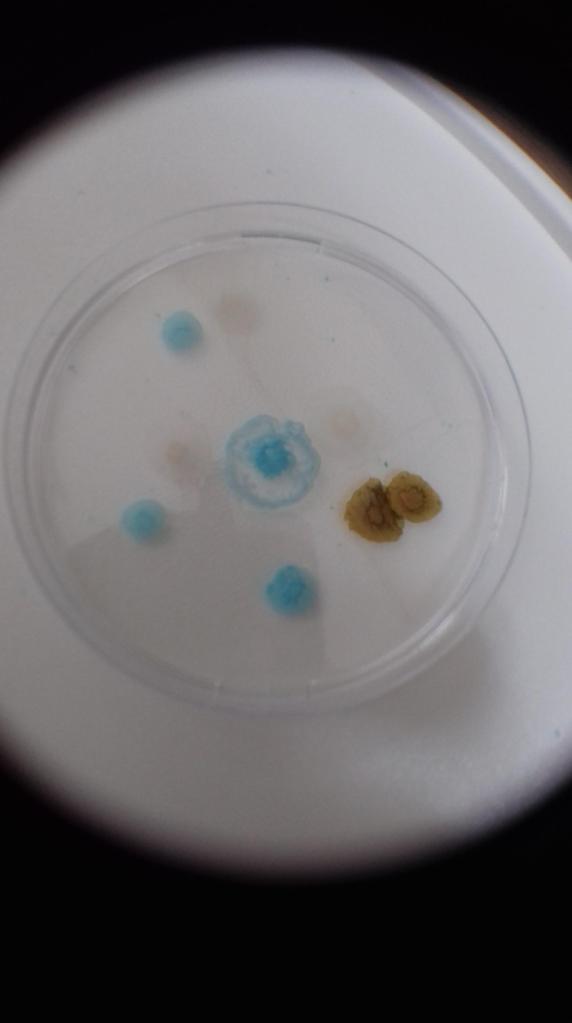

This week we are learning from the REAL ‘expert’ on ‘homeschooling’ – my fifteen-year-old multiply neurodivergent daughter, @PanKwake. She has been home educated for almost a decade, only attending school for a bit more than a year. Due to bullying and the school’s inability to meet her complex needs, including PDA, ASD, ADHD, dyslexia, dyspraxia, yadda-yadda-yadda…
@PanKwake was thrilled when I asked her to share some of her favorite resources with those families forced to ‘lockdown learn.’ I don’t think I even finished getting the words out of my mouth before she was pulling up websites and YouTube channels she wanted other to know about. She’s a tough cookie when it comes to keeping her focused, but one thing that self-directed learning has done for her is to keep that innate curiosity and thirst for knowledge alive. I know that schools would have extinguished that long ago.
But after all those YouTube channels yesterday and more gaming resources to come, I don’t want you to think that she NEVER gets offline. She does…occasionally. So, today, I am focusing on her STEM and art resources. Please note: We do NOT receive any form of compensation from any of these products. These are all products that we have been using for years and pay full retail for.
Of course, we recognize the middle-class privilege that allows us to purchase these things for @PanKwake. Before Covid, we shared most of these experiences with our friends, home educated or schoolers. One day we hope to again. That may also be an option for others to share the expense of these products. They are all certainly something that we think is worth it.
If you are not familiar with the term STEM, it refers to Science, Technology, Engineering & Mathematics. So we will begin with those products…
This company provides 2-3 chemistry experiments per monthly kit. There are enough materials to repeat each experiment at least twice. What’s more their website and app provides an excellent lesson explaining the principles behind each reaction.
These products are clearly for older children (even 10-year-olds should be supervised). But honestly, the quality of instruction is superior to my American high school chemistry. It is the priciest of all these products, so unless your child is a science or chemistry geek, this might not be the best investment.
This company offers a range of products from the early-years to teens. Each crate comes with two projects to build. KiWiCo. focuses primarily upon the engineering and physics side of science. We actually have two subscriptions – the original Kiwi Crate for 5-8 and the Tinker Crate for 9-16.




Moving away from STEM and the sciences to more liberal arts, we have…
Yum Boxes from Universal Yums
Have you ever wondered what snack foods people eat around the world? Look no further, these monthly care packages from around the world feature crisps, chocolate, biscuits, and more from a different country every month. They also include a wonderful booklet that highlights the history and culture in that country.


@PanKwake like many autistic people struggles with new tastes and textures. Yum boxes has encouraged her explore new foods. Of course, she usually spits most of them out, always refuses to try one or two based on smell alone, and goes through two or three glasses of water to neutralize the taste of the ones she doesn’t like. But considering her usual menu consists of only about three dozen options, that’s a big deal.
This one is especially fun when experienced with friends. And these are full size packets so there is almost always enough to share with half a dozen people. I do feel guilty about the ones that end up in the food bin, but generally we are able to rehome most of the box to our friends.
@PanKwake has always been into art. But recently, she seems to have found her niche – her medium.
@PanKwake first discovered this serious upgrade from Play Dough at an autism show. She fell in love. Her first tries were challenging, but these days, well, see for yourself…

And that is a very small percentage of her body of work. We buy the stuff by the box full every couple of months. It air dries in a couple of days and makes great presents for grandmothers, neighbors, and friends.
Of course, these are just her favorites. There are many art projects that you can make out of recyclables. And most of you have a volcano science experiment in your pantry (baking soda and vinegar is all it takes). Or oobleck (2 parts cornstarch to 1 part water).
The beauty of ‘homeschooling’ is that learning is everywhere. And it is a heck of a lot more fun than sitting at some desk and listening to a teacher drone on from a national curriculum. Heck, if you ain’t careful, those kids might go back to school knowing so much that they are ahead of the rest of the class wo sat at the table doing worksheets.
While @PanKwake has learning challenges, I promise you there is nothing dumb about that girl. She is living proof that our children will learn…despite us.
Tomorrow, we’ll go back to those technologies and look at some of @PanKwake’s favorite educational games.